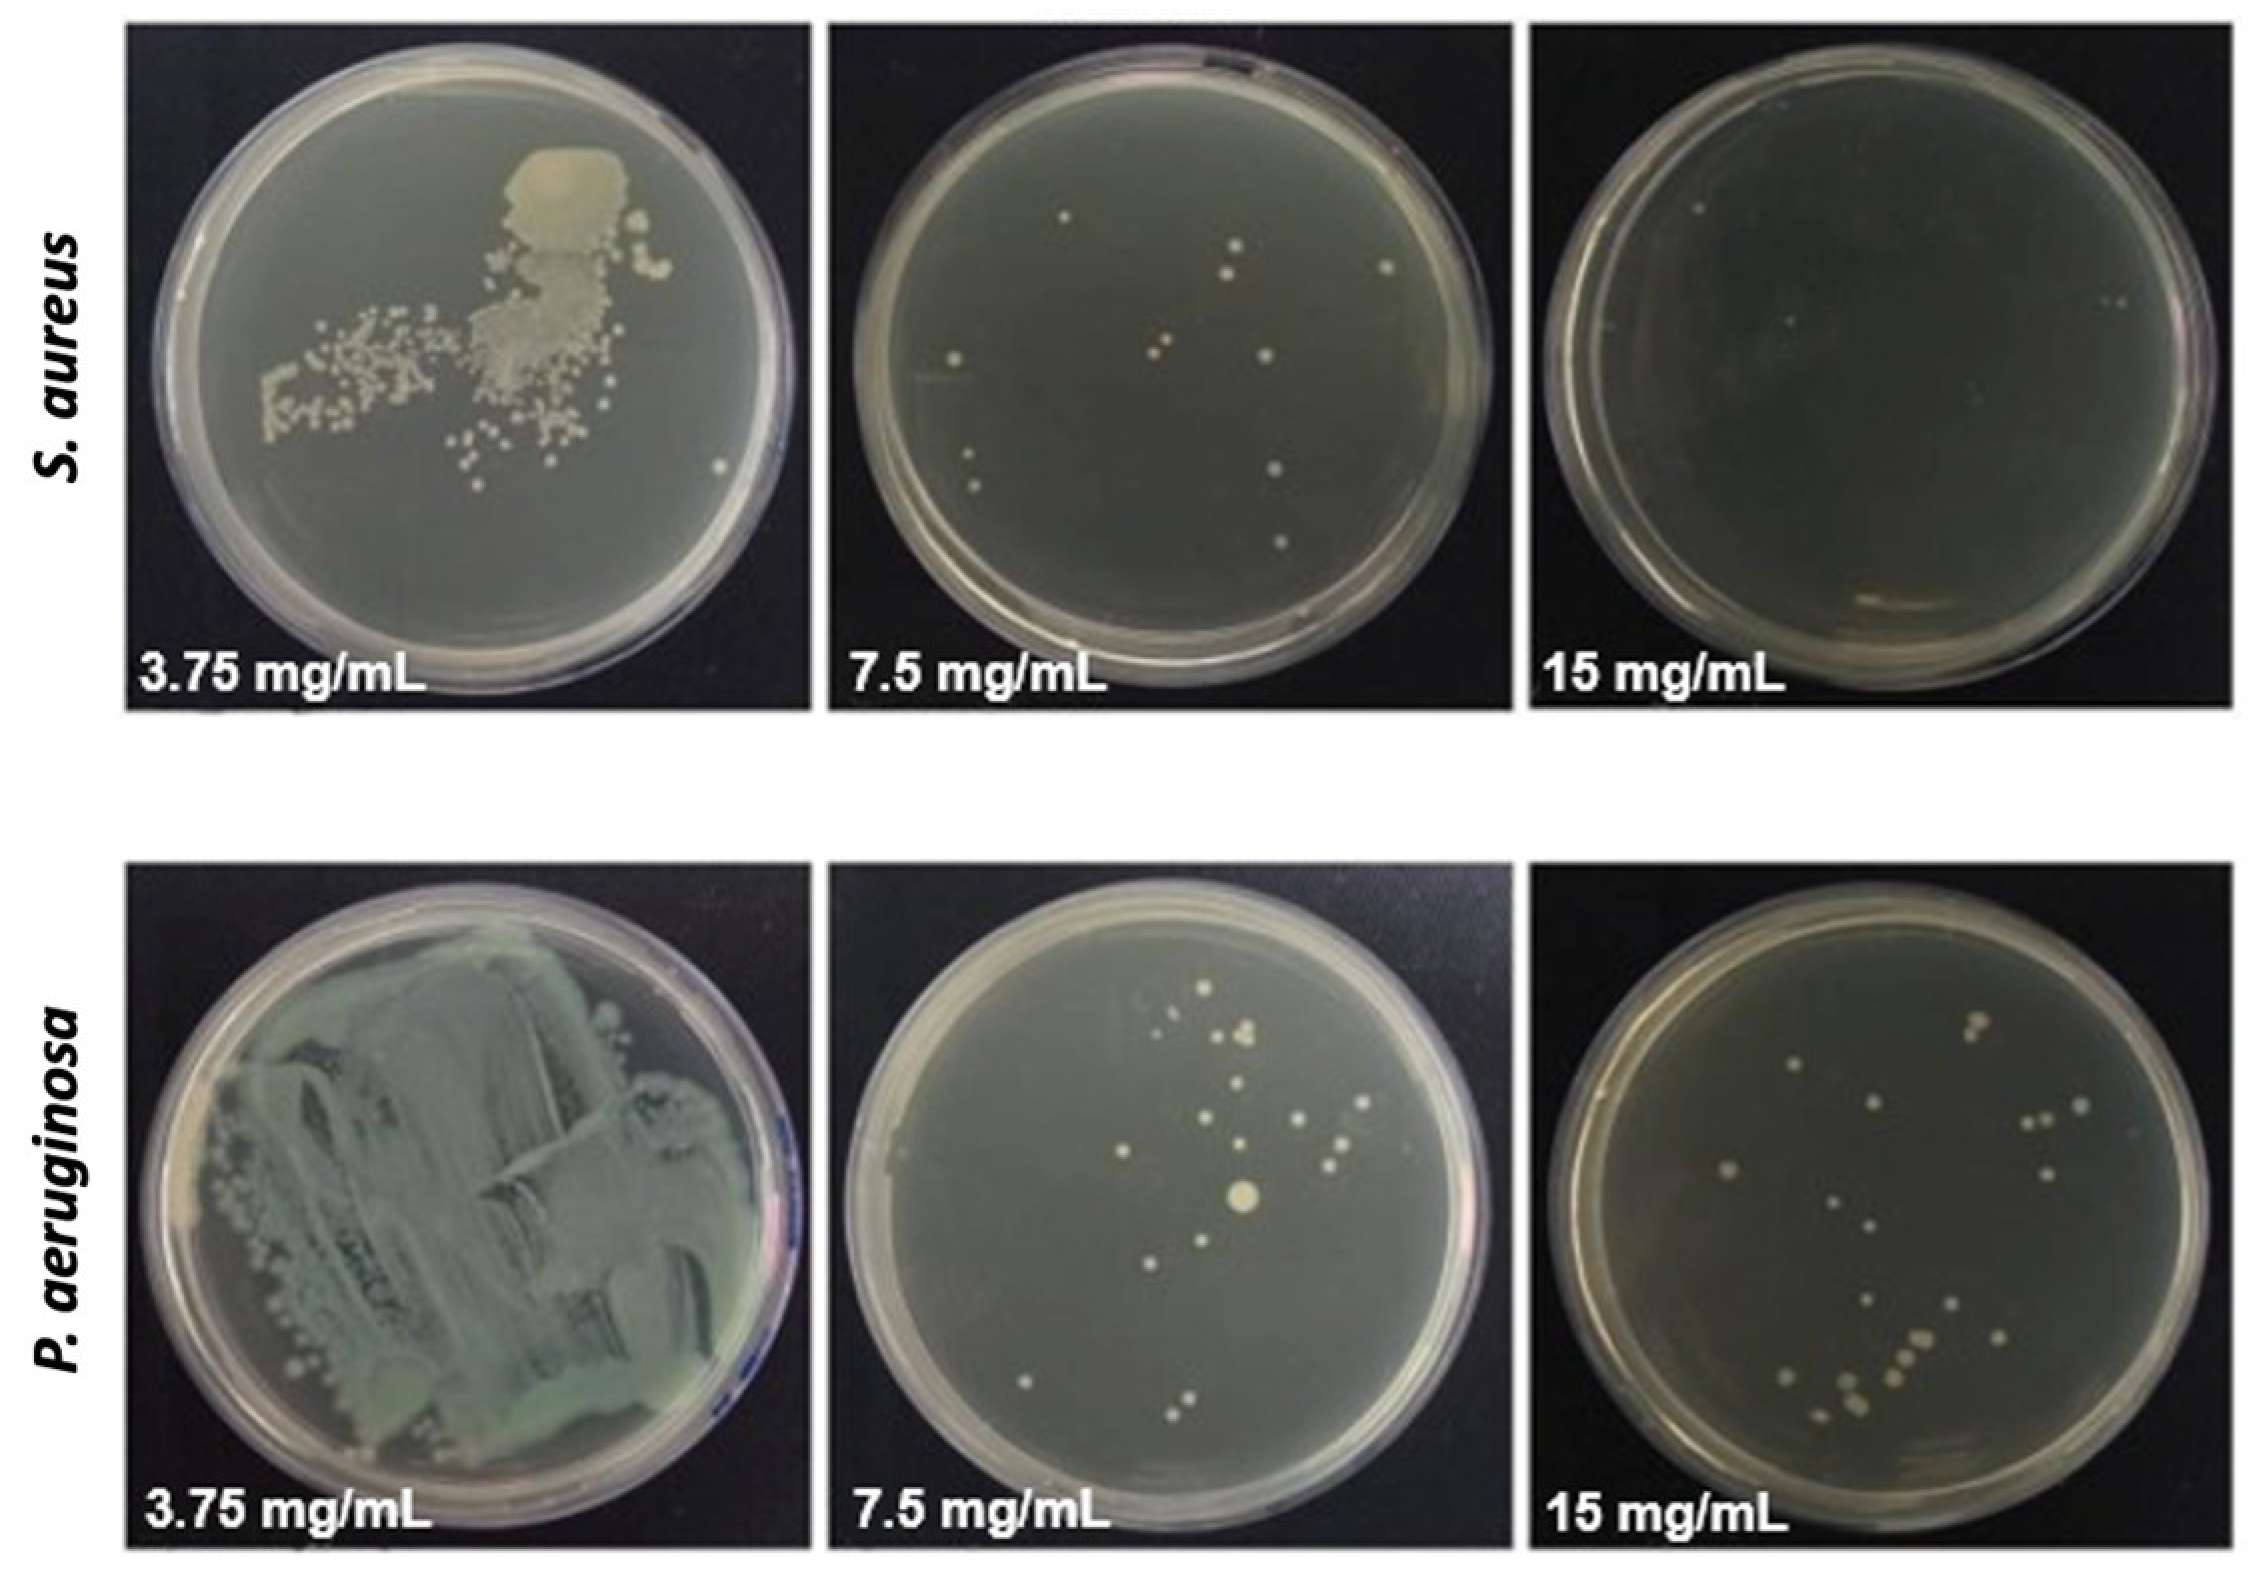
Processes 12 02330 g006

Electrospun Fibers of Ecovio® Polymer Blends with Antimicrobial Tea Tree Essential Oil: Enhanced Chemical and Biological Properties
Abstract
1. Introduction
2. Materials and Methods
2.1. Materials
2.2. Electrospun Solutions, Electrospinning, and Fiber Preparation
2.3. Fiber Characterization
2.4. Antimicrobial Assay with the Tea Tree Essential Oil and Fibers
2.5. Anti-Adhesive Assay with Bacteria
2.6. Platelet Adhesion Assay
2.7. Whole Blood Coagulation Assay
2.8. Statistical Analysis
3. Results and Discussion
3.1. Solution Properties
3.2. Fiber Characterization
3.3. Antimicrobial Activity of the Tea Tree Essential Oil
3.4. Antiadhesive and Antimicrobial Activity of the Fibers
3.5. Blood Coagulation
4. Conclusions
Author Contributions
Funding
Data Availability Statement
Acknowledgments
Conflicts of Interest
References
- Butnariu, M.; Sarac, I. Essential Oils from Plants. JBBS 2018, 1, 35–43. [Google Scholar] [CrossRef]
- Siddiqui, T.; Khan, M.U.; Sharma, V.; Gupta, K. Terpenoids in Essential Oils: Chemistry, Classification, and Potential Impact on Human Health and Industry. Phytomed. Plus 2024, 4, 100549. [Google Scholar] [CrossRef]
- Abers, M.; Schroeder, S.; Goelz, L.; Sulser, A.; St. Rose, T.; Puchalski, K.; Langland, J. Antimicrobial Activity of the Volatile Substances from Essential Oils. BMC Complement. Med. Ther. 2021, 21, 124. [Google Scholar] [CrossRef] [PubMed]
- Miguel, M.G. Antioxidant and Anti-Inflammatory Activities of Essential Oils: A Short Review. Molecules 2010, 15, 9252–9287. [Google Scholar] [CrossRef] [PubMed]
- Graßmanna, J.; Hippelia, S.; Dornischa, K.; Rohnerta, U.; Beuscherb, N.; Elstnera, E. Antioxidant Properties of Essential Oils. Arzneimittelforschung 2011, 50, 135–139. [Google Scholar] [CrossRef]
- Durczyńska, Z.; Żukowska, G. Properties and Applications of Essential Oils: A Review. J. Ecol. Eng. 2024, 25, 333–340. [Google Scholar] [CrossRef]
- Kashyap, R. Exploring the Molecular Mechanisms and Therapeutic Potentials of Essential Oils: A Systems Biology Approach. Future Integr. Med. 2024, 3, 116–131. [Google Scholar] [CrossRef]
- Galgano, M.; Capozza, P.; Pellegrini, F.; Cordisco, M.; Sposato, A.; Sblano, S.; Camero, M.; Lanave, G.; Fracchiolla, G.; Corrente, M.; et al. Antimicrobial Activity of Essential Oils Evaluated In Vitro against Escherichia coli and Staphylococcus aureus. Antibiotics 2022, 11, 979. [Google Scholar] [CrossRef]
- Chin, K.B.; Cordell, B. The Effect of Tea Tree Oil (Melaleuca alternifolia) on Wound Healing Using a Dressing Model. J. Altern. Complement. Med. 2013, 19, 942–945. [Google Scholar] [CrossRef]
- Carson, C.F.; Riley, T.V. Antimicrobial Activity of the Essential Oil of Melaleuca alternifolia. Lett. Appl. Microbiol. 1993, 16, 49–55. [Google Scholar] [CrossRef]
- Lee, J.Y.; Lee, J.; Ko, S.W.; Son, B.C.; Lee, J.H.; Kim, C.S.; Park, C.H. Fabrication of Antibacterial Nanofibrous Membrane Infused with Essential Oil Extracted from Tea Tree for Packaging Applications. Polymers 2020, 12, 125. [Google Scholar] [CrossRef] [PubMed]
- Carson, C.F.; Hammer, K.A.; Riley, T.V. Melaleuca alternifolia (Tea Tree) Oil: A Review of Antimicrobial and Other Medicinal Properties. Clin. Microbiol. Rev. 2006, 19, 50–62. [Google Scholar] [CrossRef] [PubMed]
- Labib, R.M.; Ayoub, I.M.; Michel, H.E.; Mehanny, M.; Kamil, V.; Hany, M.; Magdy, M.; Moataz, A.; Maged, B.; Mohamed, A. Appraisal on the Wound Healing Potential of Melaleuca alternifolia and Rosmarinus officinalis L. Essential Oil-Loaded Chitosan Topical Preparations. PLoS ONE 2019, 14, e0219561. [Google Scholar] [CrossRef]
- Cox, S.D.; Mann, C.M.; Markham, J.L. Interactions between Components of the Essential Oil of Melaleuca alternifolia. J. Appl. Microbiol. 2001, 91, 492–497. [Google Scholar] [CrossRef]
- Brophy, J.J.; Davies, N.W.; Southwell, I.A.; Stiff, I.A.; Williams, L.R. Gas Chromatographic Quality Control for Oil of Melaleuca Terpinen-4-Ol Type (Australian Tea Tree). J. Agric. Food Chem. 1989, 37, 1330–1335. [Google Scholar] [CrossRef]
- Oliveira, A.C.M.; Fontana, A.; Negrini, T.C.; Nogueira, M.N.M.; Bedran, T.B.L.; Andrade, C.R.; Spolidorio, L.C.; Spolidorio, D.M.P. Emprego Do Óleo de Melaleuca alternifolia Cheel (Myrtaceae) Na Odontologia: Perspectivas Quanto à Utilização Como Antimicrobiano Alternativo Às Doenças Infecciosas de Origem Bucal. Rev. Bras. Plantas Med. 2011, 13, 492–499. [Google Scholar] [CrossRef]
- Crawford, G.H.; Sciacca, J.R.; James, W.D. Tea Tree Oil: Cutaneous Effects of the Extracted Oil of Melaleuca alternifolia. Dermatitis (Am. J. Contact Dermat.) 2004, 15, 59. [Google Scholar] [CrossRef]
- Pazyar, N.; Yaghoobi, R.; Bagherani, N.; Kazerouni, A. A Review of Applications of Tea Tree Oil in Dermatology. Int. J. Dermatol. 2013, 52, 784–790. [Google Scholar] [CrossRef]
- Khanna, M. Allergic Contact Dermatitis to Tea Tree Oil with Erythema Multiforme–like ID Reaction. Am. J. Contact Dermat. 2000, 11, 238–242. [Google Scholar] [CrossRef]
- Tarach, I.; Olewnik-Kruszkowska, E.; Richert, A.; Gierszewska, M.; Rudawska, A. Influence of Tea Tree Essential Oil and Poly(Ethylene Glycol) on Antibacterial and Physicochemical Properties of Polylactide-Based Films. Materials 2020, 13, 4953. [Google Scholar] [CrossRef]
- Zhu, L.; Machmudah, S.; Wahyudiono; Kanda, H.; Goto, M. Reduced-Pressure Process for Fabricating Tea Tree Oil—Polyvinylpyrrolidone Electrospun Fibers. Polymers 2022, 14, 743. [Google Scholar] [CrossRef] [PubMed]
- Maheshwari, S.; Chang, H.-C. Assembly of Multi-Stranded Nanofiber Threads through AC Electrospinning. Adv. Mater. 2009, 21, 349–354. [Google Scholar] [CrossRef]
- Bhardwaj, N.; Kundu, S.C. Electrospinning: A Fascinating Fiber Fabrication Technique. Biotechnol. Adv. 2010, 28, 325–347. [Google Scholar] [CrossRef]
- Leung, V.; Ko, F. Biomedical Applications of Nanofibers. Polym. Adv. Technol. 2011, 22, 350–365. [Google Scholar] [CrossRef]
- Partheniadis, I.; Stathakis, G.; Tsalavouti, D.; Heinämäki, J.; Nikolakakis, I. Essential Oil—Loaded Nanofibers for Pharmaceutical and Biomedical Applications: A Systematic Mini-Review. Pharmaceutics 2022, 14, 1799. [Google Scholar] [CrossRef]
- Martins, A.F.; Facchi, S.P.; Da Câmara, P.C.F.; Camargo, S.E.A.; Camargo, C.H.R.; Popat, K.C.; Kipper, M.J. Novel Poly(ε-Caprolactone)/Amino-Functionalized Tannin Electrospun Membranes as Scaffolds for Tissue Engineering. J. Colloid Interface Sci. 2018, 525, 21–30. [Google Scholar] [CrossRef]
- Plath, A.M.S.; Facchi, S.P.; Souza, P.R.; Sabino, R.M.; Corradini, E.; Muniz, E.C.; Popat, K.C.; Filho, L.C.; Kipper, M.J.; Martins, A.F. Zein Supports Scaffolding Capacity toward Mammalian Cells and Bactericidal and Antiadhesive Properties on Poly(ε-Caprolactone)/Zein Electrospun Fibers. Mater. Today Chem. 2021, 20, 100465. [Google Scholar] [CrossRef]
- Mani, M.P.; Mohd Faudzi, A.A.; Ramakrishna, S.; Ismail, A.F.; Jaganathan, S.K.; Tucker, N.; Rathanasamy, R. Sustainable Electrospun Materials with Enhanced Blood Compatibility for Wound Healing Applications—A Mini Review. Curr. Opin. Biomed. Eng. 2023, 27, 100457. [Google Scholar] [CrossRef]
- Jiao, J.; Peng, C.; Li, C.; Qi, Z.; Zhan, J.; Pan, S. Dual Bio-Active Factors with Adhesion Function Modified Electrospun Fibrous Scaffold for Skin Wound and Infections Therapeutics. Sci. Rep. 2021, 11, 457. [Google Scholar] [CrossRef]
- Simas, S.M. O Tratamento de Feridas Cutâneas em Cães e Gatos; Universidade Federal do Rio Grande do Sul: Farroupilha, Brazil, 2010; Available online: https://hdl.handle.net/10183/39023 (accessed on 1 August 2024).
- Rothwell, S.W.; Fudge, J.M.; Chen, W.-K.; Reid, T.J.; Krishnamurti, C. Addition of a Propyl Gallate-Based Procoagulant to a Fibrin Bandage Improves Hemostatic Performance in a Swine Arterial Bleeding Model. Thromb. Res. 2002, 108, 335–340. [Google Scholar] [CrossRef]
- Rahmawati, S.I.; Izzati, F.N.; Hapsari, Y.; Septiana, E.; Rachman, F.; Bustanussalam; Simanjuntak, P. Endophytic Microbes and Antioxidant Activities of Secondary Metabolites from Mangroves Avicennia Marina and Xylocarpus Granatum. IOP Conf. Ser. Earth Environ. Sci. 2019, 278, 012065. [Google Scholar] [CrossRef]
- Li, D.; Wang, Y.; Xia, Y. Electrospinning Nanofibers as Uniaxially Aligned Arrays and Layer-by-Layer Stacked Films. Adv. Mater. 2004, 16, 361–366. [Google Scholar] [CrossRef]
- Facchi, D.P.; Souza, P.R.; Almeida, V.C.; Bonafé, E.G.; Martins, A.F. Optimizing the Ecovio® and Ecovio®/Zein Solution Parameters to Achieve Electrospinnability and Provide Thin Fibers. J. Mol. Liq. 2021, 321, 114476. [Google Scholar] [CrossRef]
- Facchi, D.P.; Lima, A.C.; de Oliveira, J.H.; Lazarin-Bidóia, D.; Nakamura, C.V.; Canesin, E.A.; Bonafé, E.G.; Monteiro, J.P.; Visentainer, J.V.; Muniz, E.C.; et al. Polyelectrolyte Complexes Based on Alginate/Tanfloc: Optimization, Characterization and Medical Application. Int. J. Biol. Macromol. 2017, 103, 129–138. [Google Scholar] [CrossRef]
- Vaccioli, K. Estudo da Blenda PBAT/PLA Com Cargas; Mestrado em Engenharia Metalúrgica e de Materiais, Universidade de São Paulo: São Paulo, Brazil, 2016. [Google Scholar]
- Sperling, L.H. Polymeric Multicomponent Materials: An Introduction; Wiley: New York, NY, USA, 1997; ISBN 978-0-471-04138-2. [Google Scholar]
- Romero, R.; Chubb, L.; Travers, J.K.; Gonzales, T.R.; Ehrhart, N.P.; Kipper, M.J. Coating Cortical Bone Allografts with Periosteum-Mimetic Scaffolds Made of Chitosan, Trimethyl Chitosan, and Heparin. Carbohydr. Polym. 2015, 122, 144–151. [Google Scholar] [CrossRef]
- Balouiri, M.; Sadiki, M.; Ibnsouda, S.K. Methods for in Vitro Evaluating Antimicrobial Activity: A Review. J. Pharm. Anal. 2016, 6, 71–79. [Google Scholar] [CrossRef]
- Da Silva, A.B.; Facchi, S.P.; Bezerra, F.M.; Lis, M.J.; Monteiro, J.P.; Bonafé, E.G.; Rubira, A.F.; Martins, A.F. Antimicrobial Composites Based on Methacrylic Acid–Methyl Methacrylate Electrospun Fibers Stabilized with Copper(II). Molecules 2024, 29, 2835. [Google Scholar] [CrossRef]
- Tedesco, L.; Bufalo, A.C.; Wietzikoski, E.C.; Velasquez, P.A.G.; Ciesca, G.M. Avaliação antibacteriana do extrato de melaleuca (Melaleuca alternifolia) frente à cepa de Staphylococcus aureus. Arq. Ciências Saúde Univ. Parana. (NIPAR) 2014, 18, 89–94. [Google Scholar] [CrossRef]
- Controle Interno Da Qualidade Para Testes de Sensibilidade a Antimicrobianos.Pdf—Agência Nacional de Vigilância Sanitária—Anvisa. Available online: https://www.gov.br/anvisa/pt-br/centraisdeconteudo/publicacoes/servicosdesaude/publicacoes/controle-interno-da-qualidade-para-testes-de-sensibilidade-a-antimicrobianos.pdf/view (accessed on 13 June 2024).
- da Cruz, J.A.; da Silva, A.B.; Ramin, B.B.S.; Souza, P.R.; Popat, K.C.; Zola, R.S.; Kipper, M.J.; Martins, A.F. Poly(Vinyl Alcohol)/Cationic Tannin Blend Films with Antioxidant and Antimicrobial Activities. Mater. Sci. Eng. C Mater. Biol. Appl. 2020, 107, 110357. [Google Scholar] [CrossRef]
- Madruga, L.Y.C.; Popat, K.C.; Balaban, R.C.; Kipper, M.J. Enhanced Blood Coagulation and Antibacterial Activities of Carboxymethyl-Kappa-Carrageenan-Containing Nanofibers. Carbohydr. Polym. 2021, 273, 118541. [Google Scholar] [CrossRef]
- Pavezi, K.J.P.; Rocha, A.; Bonafé, E.G.; Martins, A.F. Electrospinning-Electrospraying of Poly(Acid Lactic) Solutions in Binary Chloroform/Formic Acid and Chloroform/Acetic Acid Mixtures. J. Mol. Liq. 2020, 320, 114448. [Google Scholar] [CrossRef]
- Sibiryakov, N. Dependence of the Surfactant Solutions Surface Tension on the Concentration and on the Temperature. J. Phys. Conf. Ser. 2021, 1867, 012026. [Google Scholar] [CrossRef]
- de Oliveira, G.A.G. Efeito da Superfície Hidrofílica na Osseointegração de Implantes em sítios com Defeitos Ósseos Circunferenciais: Estudo Experimental em cães. Available online: https://repositorio.usp.br/item/002433615 (accessed on 1 August 2024).
- de Moraes, J.d.D.P. Influência Da Adição de Surfactantes Em Fibras Altamente Alinhadas de Poli (Caprolactona) Obtidas Por Eletrofiação. Doctoral Dissertation, UNICAMP, Campinas, Brazil, 2015. [Google Scholar]
- Vidal, P.; Martinez, M.; Hernandez, C.; Adhikari, A.R.; Mao, Y.; Materon, L.; Lozano, K. Development of Chromatic Biosensor for Quick Bacterial Detection Based on Polyvinyl Butyrate-Polydiacetylene Nonwoven Fiber Composites. Eur. Polym. J. 2019, 121, 109284. [Google Scholar] [CrossRef]
- Alves, A.C.d.S.B. Estudo da Influência do Óleo Essencial de Alecrim nas Propriedades de poli-(3- hidroxibutirato)/Polietilenoglicol. Available online: https://repositorio.ufpe.br/handle/123456789/31889 (accessed on 13 June 2024).
- Biblioteca Digital de Tese e Dissertação: Desenvolvimento e Caracterização de Microemulsões Contendo o Óleo Essencial de Melaleuca alternifolia. Available online: http://tede.bc.uepb.edu.br/jspui/handle/tede/3164 (accessed on 13 June 2024).
- De Groot, A.C.; Schmidt, E. Tea Tree Oil: Contact Allergy and Chemical Composition. Contact Dermat. 2016, 75, 129–143. [Google Scholar] [CrossRef]
- Lide, D.R. Handbook of Data on Organic Compounds, 3rd ed.; Lide, D.R., Milne, G.W.A., Eds.; CRC Press: Boca Raton, FL, USA, 1994; ISBN 978-0-8493-0445-3. [Google Scholar]
- Loughlin, R.; Gilmore, B.F.; McCarron, P.A.; Tunney, M.M. Comparison of the Cidal Activity of Tea Tree Oil and Terpinen-4-Ol against Clinical Bacterial Skin Isolates and Human Fibroblast Cells. Lett. Appl. Microbiol. 2008, 46, 428–433. [Google Scholar] [CrossRef]
- Banes-Marshall, L.; Cawley, P.; Phillips, C.A. In Vitro Activity of Melaleuca alternifolia (Tea Tree) Oil against Bacterial and Candida Spp. Isolates from Clinical Specimens. Br. J. Biomed. Sci. 2001, 58, 139–145. [Google Scholar]
- Stover, C.K.; Pham, X.Q.; Erwin, A.L.; Mizoguchi, S.D.; Warrener, P.; Hickey, M.J.; Brinkman, F.S.L.; Hufnagle, W.O.; Kowalik, D.J.; Lagrou, M.; et al. Complete Genome Sequence of Pseudomonas Aeruginosa PAO1, an Opportunistic Pathogen. Nature 2000, 406, 959–964. [Google Scholar] [CrossRef]
- O’Loughlin, C.T.; Miller, L.C.; Siryaporn, A.; Drescher, K.; Semmelhack, M.F.; Bassler, B.L. A Quorum-Sensing Inhibitor Blocks Pseudomonas Aeruginosa Virulence and Biofilm Formation. Proc. Natl. Acad. Sci. USA 2013, 110, 17981–17986. [Google Scholar] [CrossRef]
- De Oliveira, A.C.; Madruga, L.Y.C.; Chevallier, P.; Copes, F.; Mantovani, D.; Vilsinski, B.H.; Popat, K.C.; Kipper, M.J.; Souza, P.R.; Martins, A.F. Polyphenolic Tannin-Based Polyelectrolyte Multilayers on Poly(Vinyl Chloride) for Biocompatible and Antiadhesive Coatings with Antimicrobial Properties. Prog. Org. Coat. 2024, 194, 108629. [Google Scholar] [CrossRef]

| Solutions | EC (% w/v) | TTE (mL) | TTE (% w/v) | EC/TTE (% w/w) |
|---|---|---|---|---|
| EC | 10 | 0 | 0 | 100/0 |
| EC/TTE0.5 | 9.1 | 0.5 | 8.82 | 53.1/46.9 |
| EC/TTE1.0 | 8.3 | 1.0 | 17.6 | 36.2/63.8 |
| EC/TTE1.5 | 7.7 | 1.5 | 26.4 | 27.4/72.6 |
| Solutions | Conductivity (μS/cm) | Surface Tension (mN/m) | Viscosity (mm2/s) | Size (nm) 1 | WCA (°) 1 |
|---|---|---|---|---|---|
| EC | 1.12 ± 0.12 a | 32.6 ± 0.4 a | 9.8 ± 0.2 a | 478 ± 219 a | 120 ± 2 a |
| EC/TTE0.5 | 1.07 ± 0.10 a | 28.1 ± 0.2 b | 8.3 ± 0.1 b | 393 ± 120 b | 97 ± 4 b |
| EC/TTE1.0 | 0.63 ± 0.08 b | 28.2 ± 0.2 b | 8.2 ± 0.2 b | 252 ± 51 b | 95 ± 5 b |
| EC/TTE1.5 | 0.74 ± 0.07 b | 30.1 ± 0.2 c | 6.9 ± 0.1 c | 278 ± 59 b | 69 ± 1 c |
Disclaimer/Publisher’s Note: The statements, opinions and data contained in all publications are solely those of the individual author(s) and contributor(s) and not of MDPI and/or the editor(s). MDPI and/or the editor(s) disclaim responsibility for any injury to people or property resulting from any ideas, methods, instructions or products referred to in the content. |
© 2024 by the authors. Licensee MDPI, Basel, Switzerland. This article is an open access article distributed under the terms and conditions of the Creative Commons Attribution (CC BY) license (https://creativecommons.org/licenses/by/4.0/).
Share and Cite
de Souza, B.Z.; Facchi, D.P.; Facchi, S.P.; Teodoro, C.F.; de Almeida, D.A.; Popat, K.C.; Kipper, M.J.; Bonafé, E.G.; Martins, A.F. Electrospun Fibers of Ecovio® Polymer Blends with Antimicrobial Tea Tree Essential Oil: Enhanced Chemical and Biological Properties. Processes 2024, 12, 2330. https://doi.org/10.3390/pr12112330
de Souza BZ, Facchi DP, Facchi SP, Teodoro CF, de Almeida DA, Popat KC, Kipper MJ, Bonafé EG, Martins AF. Electrospun Fibers of Ecovio® Polymer Blends with Antimicrobial Tea Tree Essential Oil: Enhanced Chemical and Biological Properties. Processes. 2024; 12(11):2330. https://doi.org/10.3390/pr12112330
Chicago/Turabian Stylede Souza, Bianca Z., Débora P. Facchi, Suelen P. Facchi, Carlos F. Teodoro, Débora A. de Almeida, Ketul C. Popat, Matt J. Kipper, Elton G. Bonafé, and Alessandro F. Martins. 2024. "Electrospun Fibers of Ecovio® Polymer Blends with Antimicrobial Tea Tree Essential Oil: Enhanced Chemical and Biological Properties" Processes 12, no. 11: 2330. https://doi.org/10.3390/pr12112330
APA Stylede Souza, B. Z., Facchi, D. P., Facchi, S. P., Teodoro, C. F., de Almeida, D. A., Popat, K. C., Kipper, M. J., Bonafé, E. G., & Martins, A. F. (2024). Electrospun Fibers of Ecovio® Polymer Blends with Antimicrobial Tea Tree Essential Oil: Enhanced Chemical and Biological Properties. Processes, 12(11), 2330. https://doi.org/10.3390/pr12112330

